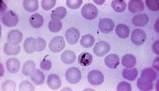
Meccanismi della divisione cellulare: dall'anello contrattile agli ioni Ca++

Concetti Chiave
- La divisione cellulare comprende due eventi principali: mitosi e citodieresi, esclusi batteri e alcune cellule genitali.
- La mitosi produce due nuclei figli geneticamente identici, preceduta dalla duplicazione del DNA.
- La citodieresi inizia verso la fine dell'anafase, dividendo il citoplasma grazie a un anello contrattile.
- Le cellule figlie risultanti sono più piccole e con meno citoplasma, ma geneticamente identiche alla cellula madre.
- In alcuni casi, come nel fegato, il citoplasma può non dividersi, formando cellule binucleate o plurinucleate.
Divisione cellulare e mitosi
In tutte le cellule, tranne i batteri e alcune cellule dell’apparato genitale, la divisione cellulare è costituita da due eventi. La mitosi, o divisione del nucleo, avviene per prima. Il secondo evento è la citodieresi, la divisione del citoplasma che inizia quando la mitosi è quasi completata.
• La mitosi porta alla formazione di due nuclei figli contenenti esattamente gli stessi geni del nucleo di partenza. Come abbiamo visto sopra, la mitosi è preceduta dalla duplicazione del DNA, cosicché per un breve tempo il nucleo della cellula contiene una doppia dose di geni. Quando il nucleo si divide, ciascuna delle due cellule figlie risulterà avere esattamente le stesse informazioni genetiche della cellula madre di partenza e dell’originaria cellula uovo fecondata da cui è derivata.
Processo di citodieresi
• La citodieresi, o divisione del citoplasma, di solito inizia verso la fine dell’anafase e si completa durante la telofase. All’equatore della cellula, a livello della linea mediana del fuso, un anello contrattile di microfilamenti forma un solco di divisione che, contraendosi sempre più, alla fine divide la massa iniziale di citoplasma in due parti. Così, alla fine della divisione cellulare si sono formate due cellule figlie. Ciascuna è più piccola e ha meno citoplasma della cellula madre, ma è geneticamente identica a essa. Le cellule figlie si accrescono e svolgono le loro normali attività finché non si dividono a loro volta.
Eccezioni e implicazioni patologiche
La mitosi e la citodieresi di solito procedono insieme, ma in certi casi il citoplasma non si divide e questo porta alla formazione di cellule binucleate o plurinucleate. Questo è abbastanza comune nel fegato. A seconda del tipo di tessuto la divisione cellulare può impiegare da cinque minuti a diverse ore per completarsi. Alla base di tumori e neoplasie sta un meccanismo di mitosi incontrollato.
Domande da interrogazione
- Qual è il ruolo della mitosi nella divisione cellulare?
- Come avviene la citodieresi e qual è il suo risultato finale?
- Quali sono le eccezioni nel processo di divisione cellulare e le loro implicazioni?
La mitosi è il processo di divisione del nucleo che porta alla formazione di due nuclei figli contenenti esattamente gli stessi geni del nucleo di partenza, garantendo che le cellule figlie abbiano le stesse informazioni genetiche della cellula madre.
La citodieresi inizia verso la fine dell'anafase e si completa durante la telofase, con un anello contrattile di microfilamenti che divide il citoplasma in due parti, formando due cellule figlie più piccole ma geneticamente identiche alla cellula madre.
In alcuni casi, il citoplasma non si divide, portando alla formazione di cellule binucleate o plurinucleate, comune nel fegato. Un meccanismo di mitosi incontrollato è alla base di tumori e neoplasie.

Accedi a tutti gli appunti
Accedi a tutti gli appunti
 Tutor AI: studia meglio e in meno tempo
Tutor AI: studia meglio e in meno tempo